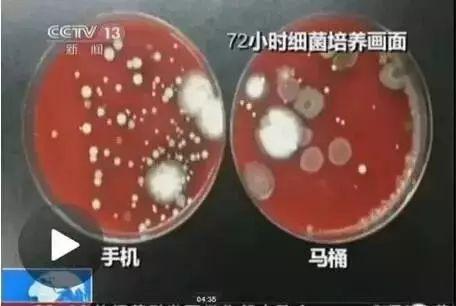

为啥你用的面膜很鸡肋?
说好的美白、祛痘、淡斑、缩毛孔,,怎么P用不管?仙女们该深有体会,不少网红面膜,名声大,效果却几乎为零!以至不少人消极认为:面膜这东西只是心理作用。
是被坑了吗?人家该有的成分可一点没少!那为啥不管用?真相只有一个:你的皮肤吸收不了!
毛孔堵塞=面膜营养流失!
皮肤长期暴露在外面,毛孔会不断堆积脏东西,无时无刻对着电脑手机,加剧面部细菌滋生,加上彩妆清洁不到位,你的毛孔早堵的透不过气了!
手机给面部带来的细菌比马桶还多
毛孔粗大、油脂旺盛、粉刺闭口、黑头问题,多由此导致!护肤达人一直强调把脸洗干净,是有道理的!
毛孔一旦堵塞,就导致一个很严重的问题:能被皮肤吸收的,仅为水分和小分子营养物。
胶原蛋白、玻尿酸等大分子营养根本无法被皮肤吸收!说白了,敷了半天,就补了点水!还不如直接敷水膜来得实惠!
因为有效成分无法吸收,皮肤问题严重的人,不管用多贵的护肤品,都很难改善,甚至加重问题;而皮肤好的人,用大宝都效果极好,就是这个原因。
生物磁性+微电流技术
另辟蹊径的黑科技新宠
爱美胜过爱生命的泰国人,终于忍不了了!这不,来自泰国,黑科技面膜诞生了!只要吸一吸!脸上脏东西全部吸出来!超级神奇好玩!
它彻底改变传统面膜护肤模式,老老实实靠那点小缝隙输送营养?才不!它独辟蹊径,利用医美生物磁学+微电流原理,真正做到深层滋养+彻底清洁!
放张大图看一看:
黑色膏体,稠稠的,很好推开。
整套配有磁石棒,刮勺,和一次性袋子。
想看效果?宅sir亲选办公室室花——Alisa出镜给大家做个测评:
用套装自带刮勺,先将面膜涂满全脸。

再用一次性袋子包住磁石棒。
敷10~15分钟,开吸!黑色部分真的一吸就没了!脸上隐隐有种拉扯感,围观群众还说听到了滋滋声!
陈年堆积的油脂、皮屑、污垢瞬间被吸下来!看看吸出的脏东西:一大坨黄、白色油脂!少女你脸这么脏你知道不!实在辣眼睛!

黑色部分吸完,厚厚的精华就留在脸上,润润的好舒服,记住再按摩15秒左右,深层护理就完成了!
妞皮肤底子本就不错,用完磁石面膜越发细腻润滑,肤如凝脂形容毫不为过!
给大家放大看一下。Alisa用完自己都兴奋的不行,说感觉如释重负!清爽水润的受不鸟!
尤其适合问题肌肤使用。杀菌消炎,祛痘效果杠杠的!有网友专门来给宅sir投稿,让我看她神奇的祛痘效果!不仅痘没了,还白了不止一个度!
敷在脸上很快痘痘就冒白尖,白头也会排出来。
因为清洁力满分,解决黑头、白头、粉刺根本不在话下!我爱长闭口,亚洲四大神水用遍了也没用,用了几天这个黑科技就下去了!它已经是我一生推了!
这是啥?哈哈哈不卖关子了!我这就告诉你!它是来自泰国的黑(高)科技面膜——火山泥磁石美白面膜!
一上市就引发了大规模“全民来吸脸”热潮。Ins上也有各大美妆博主纷纷直播自己使用的体验。
一传到国内,护肤*党**们彻底疯狂了!掀起一片疯抢+回购热潮!
超级好玩,超级水润,肤色好看了,完全不干燥,百分百的好评堪称面膜史上的奇迹!
高科技微生物磁学原理,婴儿肌肤吸出来
传统面膜无法穿透表层,对肌肤进行深层护理。
划重点:火山磁石面膜彻底改变传统面膜缺陷,选用富含矿物质的优质死海火山泥,将微量元素渗透肌肤,活化皮肤细胞!
当然,光火山泥也不值得惊奇。它最牛的地方在于,接着划重点:运用医美界高科技微生物磁学原理,结合火山磁石,用生物磁性激活皮肤!通过改善皮肤微循环、复活皮肤微电流。
生物磁:每个生物细胞都可看作小型电池,具有激活生物细胞,促进血液循环等多种作用。美容界利用生物磁性解决了无数人的皮肤烦恼。
连皮肤防护层都拿它没办法!带着营养物质,穿透防护层,直达毛孔死角。
接着用磁石棒吸出磁化矿物,注意,这是很关键的一步!
它可以彻底带走毛孔垃圾,像吸尘器一样把脏东西彻底清除!吸完,厚厚的营养精华还留在脸上,轻轻按摩15秒,彻底完成强效护肤!
一抹一吸,从内到外,最大化滋养皮肤!用完你就会发现,完全不紧绷,后续护肤品都不需要,白白嫩嫩,越看越好看!
它并不是一款清洁面膜,而是清洁+美白+细致毛孔+抗衰面膜
很多人用清洁面膜,但用过的都知道,清洁与养护可谓天敌!
使用频繁会角质过薄、肌肤敏感,最讨厌的是,用完干燥紧绷,一点不舒服!
清洁面膜使用频繁造成面部过敏
撕拉式面膜甚至还会扩大毛孔,损伤肌肤,得不偿失!
火山泥磁石面膜就厉害了,它主打深层清洁,同时温和滋养,不伤角质,不扩大毛孔!
更惊喜的是,美白提亮效果显著!不知道得还以为打了水光针!还能调理油脂,改善毛孔!毛孔粗大的大油皮彻底得救了!万幸!
火山磁石面膜提亮效果显著
一罐在手,那些美白面膜、清洁面膜、保湿面膜、抗皱面膜通通可以丢掉了好嘛!
说起来,磁这款磁石面膜并非市面第一款,之前药妆大佬dr brandt也推出了磁力面膜,小编当时就很种草,看了看价格,额,75美金,软妹币488元!我还是丑着吧!
今天看到这款,真心忍不住了!这样的高科技,这样的原材料,只要188元好嘛!
泰国品牌更让我放心,全世界都知道泰国无假药,美妆药妆行业更是监管严格到变态!这样的好物用着实在太放心了!错过了真的要哭鼻子了!
宅sir还为大家整理了几个常见问题!
Q: 磁石不包一次性袋子可以吗?
A:绝对不可以!磁石具有强力吸附力,没包磁石的结果就是,吸下来的黑色磁粉这辈子都别想从磁石棒上清走了!别问我怎么知道的!
Q:磁石棒要贴在皮肤上吸附吗?
A:磁石不必接触皮肤,中间留0.5cm的空隙,轻轻的缓缓的滑过面部,就能感觉似乎有一把吸力还凑合的吸尘器对着你的皮肤,皮肤会感觉到微微的拉扯感。
Q:卸完面膜需要洗脸吗?
A:不需要,只需要用爽肤水擦拭即可。懒癌患者们可以省略后续所有护肤流程。
版权声明
在家原创内容,欢迎个人分享至朋友圈。
如需平台转载或商务合作,请联系
微信号:TrendsZaijia006
如需电商平台合作,请联系
邮箱:hxy@trendszaijia.com
案例图片未经同意,请勿擅自使用,侵权必究!
↓↓点击阅读原文,即可进去微店!